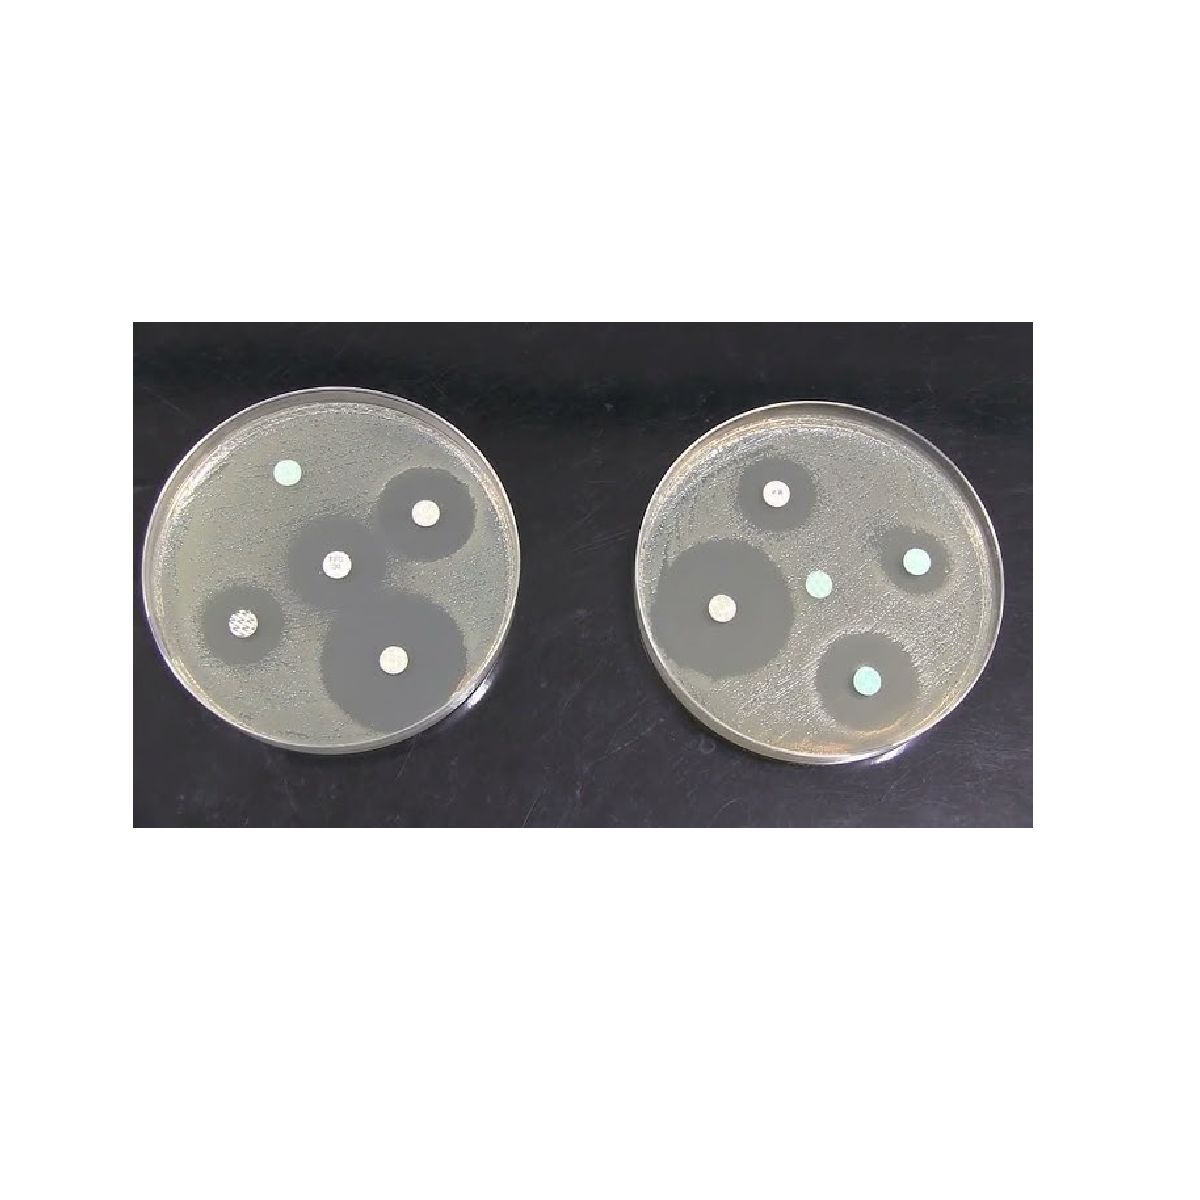

Oxoid™ Fosfomycin Antibiogram Disks, 200 µg / Discos para antibiogramas con fosfomicina Oxoid™, 200 µg
Determine la sensibilidad de los microorganismos usando métodos AST manuales y una amplia gama de discos para antibiogramas manuales de gran calidad y fácil uso.